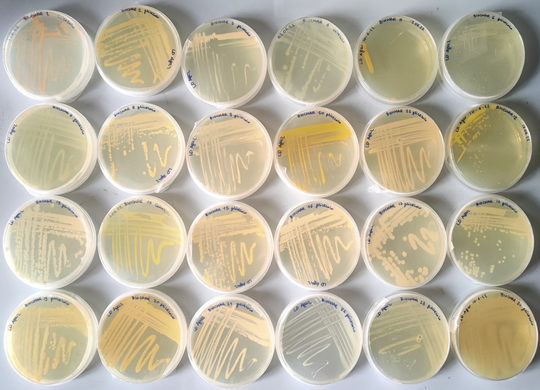

Project Objectives
This project is part of the Join Research Agreement between ENI and the University of Milano Bicocca. The aim of the project is to develop and validate a microbiologically activated biochar (Microbe-activated-Biochar (MaB)), to be applied to the biological treatment of soils contaminated by hydrocarbons. The project also aims to develop a system, composed of Microbe-activated-Biochar (MaB) and clones of plant species tolerant to organic pollutants, aimed at making efficient in situ remediation of soils contaminated by hydrocarbons through Phyto (rhizo) remediation.
General description
This product consists of a porous support material, biochar, obtained by pyrolysis from biomass and functionalized to allow adhesion to its surface, reproduction and persistence in the soil of fungi and bacteria capable of efficiently degrading hydrocarbons. Greater effectiveness in remediation could also be obtained by using this product in the soil in combination with the planting of plants suitable for living in contaminated soils (“MaB + native plant” system). This “MaB + plant” system would help make the soil (especially the deep horizons) a better environment for the reproduction / persistence of the strains of microorganisms that operate in the degradation of hydrocarbons. The functionalization of MaB with bacterial and fungal strains promoting plant growth would make the action of the microbial community and plants synergistic.
Furthermore, the use of waste biomass from industrial and agri-food production chains would lead to an increase in the degree of circularity of the remediation processes and to their greater environmental sustainability, allowing to: i) find innovative and ecological solutions to deal with pollution of the soil from hydrocarbons creating a product with zero or very low impact, ii) reducing the quantity of waste plant biomass destined for landfill and iii) introducing new forms of green business that ensure the economic sustainability of the reuse of such biomass.
Collaborators
- M3R
- ENI SpA